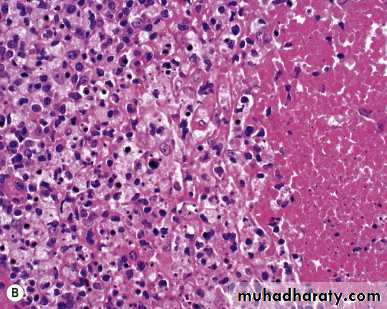
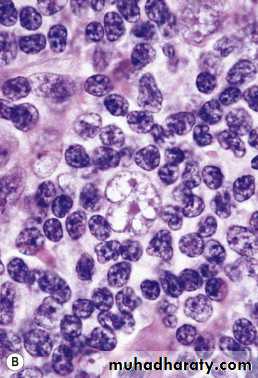

Diseases of Lympho Reticular System
Dr.KHALID WISSAMThe lymphoreticular system is involved in the defence of
the body against microorganisms and foreign substances –i.e. the immune response.
Consists of :
Thymus ,Spleen ,
Lymph nodes ,
Mucosa Associated Lymphoid Tissue (MALT) in Gut and Upper respiratory tract ,
Bone Marrow.
Lympho Reticular System
Lymph node
Under normal conditions lymph nodes are small bean shaped structuresmajor peripheral locations (e.g. cervical, axillary or inguinal) are seldom palpable.
Their primary function is to entrap foreign agents or
unwanted materials & an immune response .
Lymphadenopathy
Lymph node enlargement is an important clinical finding.Acute non specific lymphadenitis
It may be confined to local group of L.N draining focal infection , Or it may be generalized when there is bacterial or viral infection.Gross : L.N swollen tender the overlying skin is red with fluctuation if there is abscess.
Microscopic : large germinal centers, neutrophils seen around the follicles & in the sinuses, with the center of the follicles undergo necrosis result in the formation of an abscess.
Chronic non specific lymphadenitis :
It take 3 different forms :1- Follicular hyperplasia : occur in inflammatory condition that activate B lymphocyte.
It may be seen in rheumatoid arthritis , toxoplasmosis & early stage of HIV infection. characterized by:
1- preservation of L.N architecture with normal lymphoid tissue between the germinal center.
2- marked variation in shape & size of lymphoid follicles .
3-Mixed population of lymphocyte at different stage of differentiation .
4- prominent phagocytic & mitotic activity in germinal center
2-Paracortical lymphoid hyperplasia
It characterized by reactive changes in T cell region of lymph node (paracortical ) .
Microscopic :
1-Expansion of paracortical area with immunoblast .
2-hyperplasia of mononuclear phagocytic cell in the lymphatic sinuses .
3- enlargement of paracortical area that efface the lymphoid follicles.
3- Sinus histiocytosis :
Malignant lymphoma :
1- Hodgkin's disease (HD) 25%
2-Non Hodgkins lymphoma. 75%
Hodgkin's disease (HD)
It is primary disease of LN & may involve extra nodal site as secondary.
It has bimodal peak incidence ( young adult 15-35)& in fifth decade .
Male more than female .
Characterized by presence of Reed Sternberg cell (RS).
Hodgkin's disease (HD)
Gross : LN enlarge discrete later become matted & cut section is homogenous.Microscopic diagnosis depend on presence of classic RS which is large cell with abundant eosinophilic cytoplasm . binucleated (mirror image) each nucleus has eosinophilic nucleolus surround by clear zone and second a large population
of non-neoplastic inflammatory cells.
The WHO classification
Classical type:1. Nodular sclerosis
2. Mixed cellularity
3. Lymphocyte-rich
4. Lymphocyte depletion
Nodular Lymphocyte predominance HL
1-Nodular Sclerosis Type.This is the most common form of HL
Most common subtype(65%)
Frequent mediastinal involvement.Equal occurrence in males and females (F = M), most patients young adults.
Deposition of collagen in bands that divide involved lymph nodes into circumscribed nodules
Lacunar variant Reed-Sternberg cells
2-Mixed cellularity.
More than 50% present as stage III or IV disease;
M greater than F
peaking in young adults and again in adults older than 55Y
Frequent mononuclear and diagnostic RS cells; background infiltrate rich in T lymphocytes, eosinophils, macrophages, plasma cells; RS
3- Lymphocyte rich
Uncommon; M greater than F; tends to be seen in older adultsFrequent mononuclear and diagnostic RS cells; background infiltrate rich in T lymphocytes. In most cases, involved lymph nodes are diffusely effaced.
4- lymphocytic depletion.
more common in older males, HIV-infected individuals, and in developing countries; often presents with advanced disease.
Frequent diagnostic RS cells and variants and a paucity of background reactive cells
Nodular Lymphocyte predominance HL
Uncommon; young males with cervical or axillary lymphadenopathy; mediastinalFrequent L&H (popcorn cell) variants in a background of follicular dendritic cells and reactive B cells;
Clinical features:
Bimodal distribution seen in young & middle age
- painless , movable , firm usually involve cervical & mediasstinal L.N.
-hepatosplenomegaly.
-constitutional symptom(type B symptom) as low grade fever , weight loss , sweating & pruritis.
Laboratory diagnosis :
1- CBP ;
RBC : normochromic normocytic anaemia.
WBC: leukocytosis.
Platelets : normal.
2-ESR : high.
3- Lymph node biopsy.
Staging of HD:
Ann Arbor staging depend on clinical & pathological staging :
Stage 1 : involvement of L.N in single region on one side of diaphragm..
Stage 2: involvement of L.N in two region on one side of diaphragm .
Stage 3 : involvement of L.Ns i on both sides of diaphragm .
Stage 4 : multiple dissemination .
Each stage is subdivided into A (asymptomatic) & B ( has constitutional symptoms ).E (has extra nodal involvement ) .
Prognosis :
5 year survival for stage 1&2 is 100% .while for advance stage reach 50%.
Non Hodgkins lymphoma (NHL) :
* malignant neoplasm of immune system of the body.
* more common than HD.
* seen in 20-40 years .
* incidence increase due to increase in AIDS.
* majority arise from LN (65%) while in 35% has extra nodal origin .however all NHL has potential to spread to other LN , liver , B.M & spleen.
Etiology and pathogenesis :
NHL is clonal proliferation of immune cells & in 63% are of B cell origin 35% of T cell origin & 2% of histiocytic types . The following has association with NHL .
1- viral association ; EB virus are involved in endemic Burkitts lymphoma while HTLV1 associated with T cell leukaemia .
2- genetic association in the form of translocation .
3- Immunodeficiency diseases ; various inherited or acquire Immunodeficiency disease as AIDS are associated with development of NHL .
4- immunosuppression by radiation or drug may associated with development of NHL .
5- Autoimmune diseases as sjogren syndrome , SLE , non tropical sprue may lead to NHL .
Clinical features:
1- superficial lymphadenopathy as painless asymptomatic enlargement of one or more group of peripheral L.N.
2-Constitutional symptoms as fever , night sweating ,loss of body weight more than 10% .
3- Oropharyngeal involvement in 10% of cases .
4- Abdominal diseases as enlargement of liver , spleen or abdominal lymphadenopathy.
5- Other organ involvement as skin, CNS in certain type of NHL.
Laboratory Diagnosis of NHL:
In addition to clinical & histopathological features , other investigation may help in diagnosis (hematological findings):1- anemia of normochromic normocytic.
2-features of pancytopenia seen in late stages.
3-feature of leukemia seen in certain patients.
4-Bone marrow involvement by NHL seen in 20% of cases .
5- hypercalcaemia & hyperuricaemia may seen .
Prognosis :
In general low grade lymphoma progress slowly & respond to local radiation in 75% while high grade lymphoma treat by combination of radiotherapy & chemotherapy.
L.N metastatic tumors :
LN drain the site of malignant tumours usually enlarge which could be due to ;benign reactive hyperplasia or
due to metastatic deposit which occur most commonly in carcinoma & malignant melanoma
while sarcomas are uncommonly go to LN.
secondary deposit usually involve sub capsular sinuses initially later invade LN stroma.